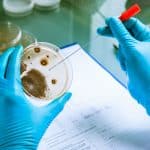
Microbiological Control

All Modules

Welcome to the future of food safety and sanitation excellence!
“Unlock a new era of food safety excellence with Qualiqo’s state-of-the-art modules. Stay informed and in control with detailed Reports and timely Notifications. Streamline your operations through our Business Process Module and maintain oversight with Administrative Monitoring. Ensure traceability, combat pests, and manage microbiological factors effectively. With Qualiqo, achieve flawless Maintenance Management, stringent Contamination Control, successful Audits, and rapid Corrective Actions. Elevate your sanitation standards and master Quality Management, all in one powerful software suite.”
Impeccable
Elevate your standards, enhance your processes, and ensure top-notch safety with Qualiqo's integrated modules.
Professional
Seamlessly manage your business with advanced modules including Reports and Notifications.
Proactive
With Qualiqo, every aspect of food safety becomes a proactive advantage.